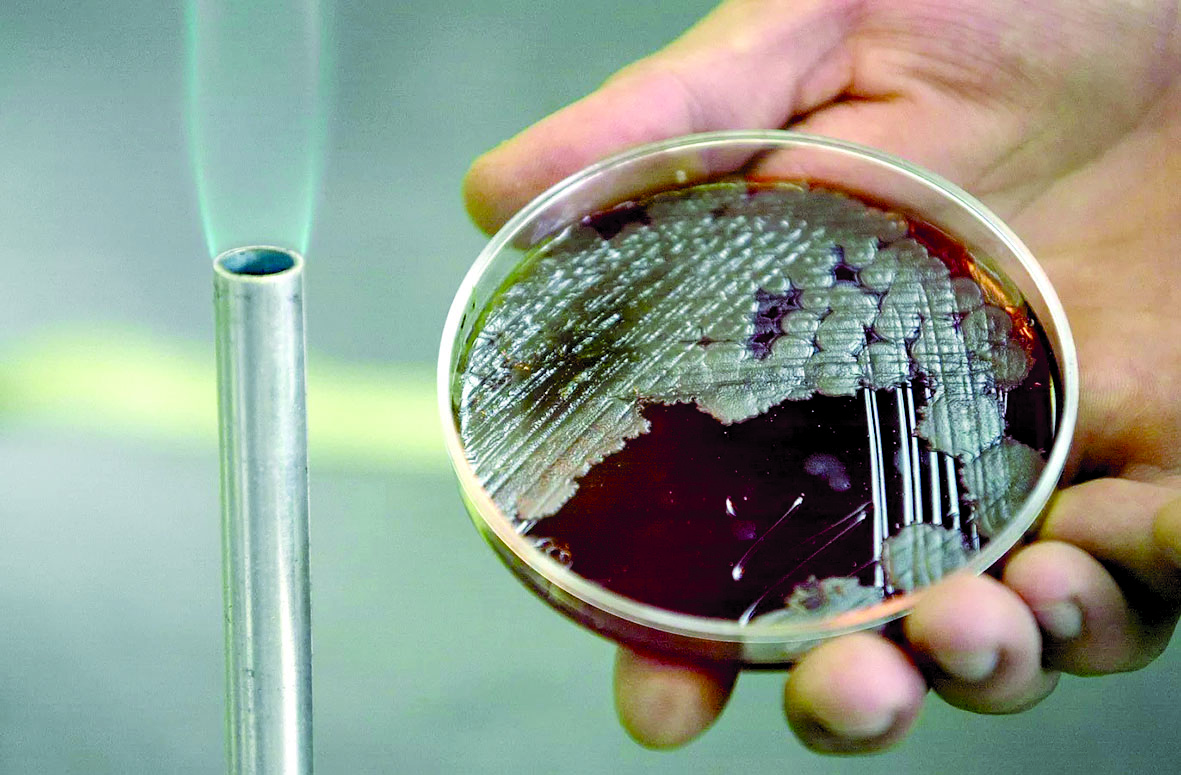
alarab

يتقدم علماء روس بخطى ثابتة في مجال الهندسة الحيوية، حيث يحولون البكتيريا – التي طالما اعتُبرت مصدراً للأمراض – إلى أدوات نافعة تخدم مجالات متنوعة تبدأ من تنظيف المدن وصولاً إلى الطب التجديدي والزراعة المستدامة.
في جامعة نوفوسيبيرسك التقنية الحكومية، طوّر فريق بقيادة آنا برونشينكو مثبطاً سائلاً للغبار يعتمد على ميكروبات التربة وبوليمرات حيوية عضوية. يُرش المركب على الطرق الحضرية ومواقع البناء ومكامن الفحم، فيشكل طبقة رقيقة تربط جزيئات الغبار وتقاوم الرياح والأمطار والتجمد حتى -40 درجة مئوية، ويمكن رشه بطائرات مسيّرة.
والمنتج غير سام، وأرخص بعشر مرات من المستورد، ويعمل كسماد طبيعي في آن واحد، ويخضع الآن لاختبارات إضافية على ملوثات أخرى.
أما في جامعة جنوب الأورال الحكومية، فقد نجح الباحثون لأول مرة في روسيا وفقا لموقع sarabic، بترميم منحوتة تذكارية للحرب في مدينة بوروفسك باستخدام خرسانة ذاتية الترميم مشبعة ببكتيريا Bacillus subtilis ولاكتات الكالسيوم.
وتنتج هذه البكتيريا معادن تسد الشقوق الدقيقة بخمس سرعة أكبر من الخرسانة التقليدية، وتعزز الكثافة وتمنع تسرب المياه. أثبتت الاختبارات فوق الصوتية استمرار العملية، مما يفتح الباب أمام استخدامها في ترميم المباني والطرق.
وفي الزراعة، ابتكر علماء جامعة الأورال الفيدرالية مبيداً حيوياً من بكتيريا جذور النباتات الملحية المستخرجة من بحيرات سيبيريا المالحة. تُنتج هذه السلالات هرمونات نباتية تحسن امتصاص النيتروجين والفوسفات وتزيد تحمل المحاصيل للملوحة، مما يرفع الكتلة الحيوية والإنتاج في ظروف الإجهاد الملحي. وتجري حالياً تجارب ميدانية على القمح والشعير بدعم من المؤسسة الروسية للعلوم.